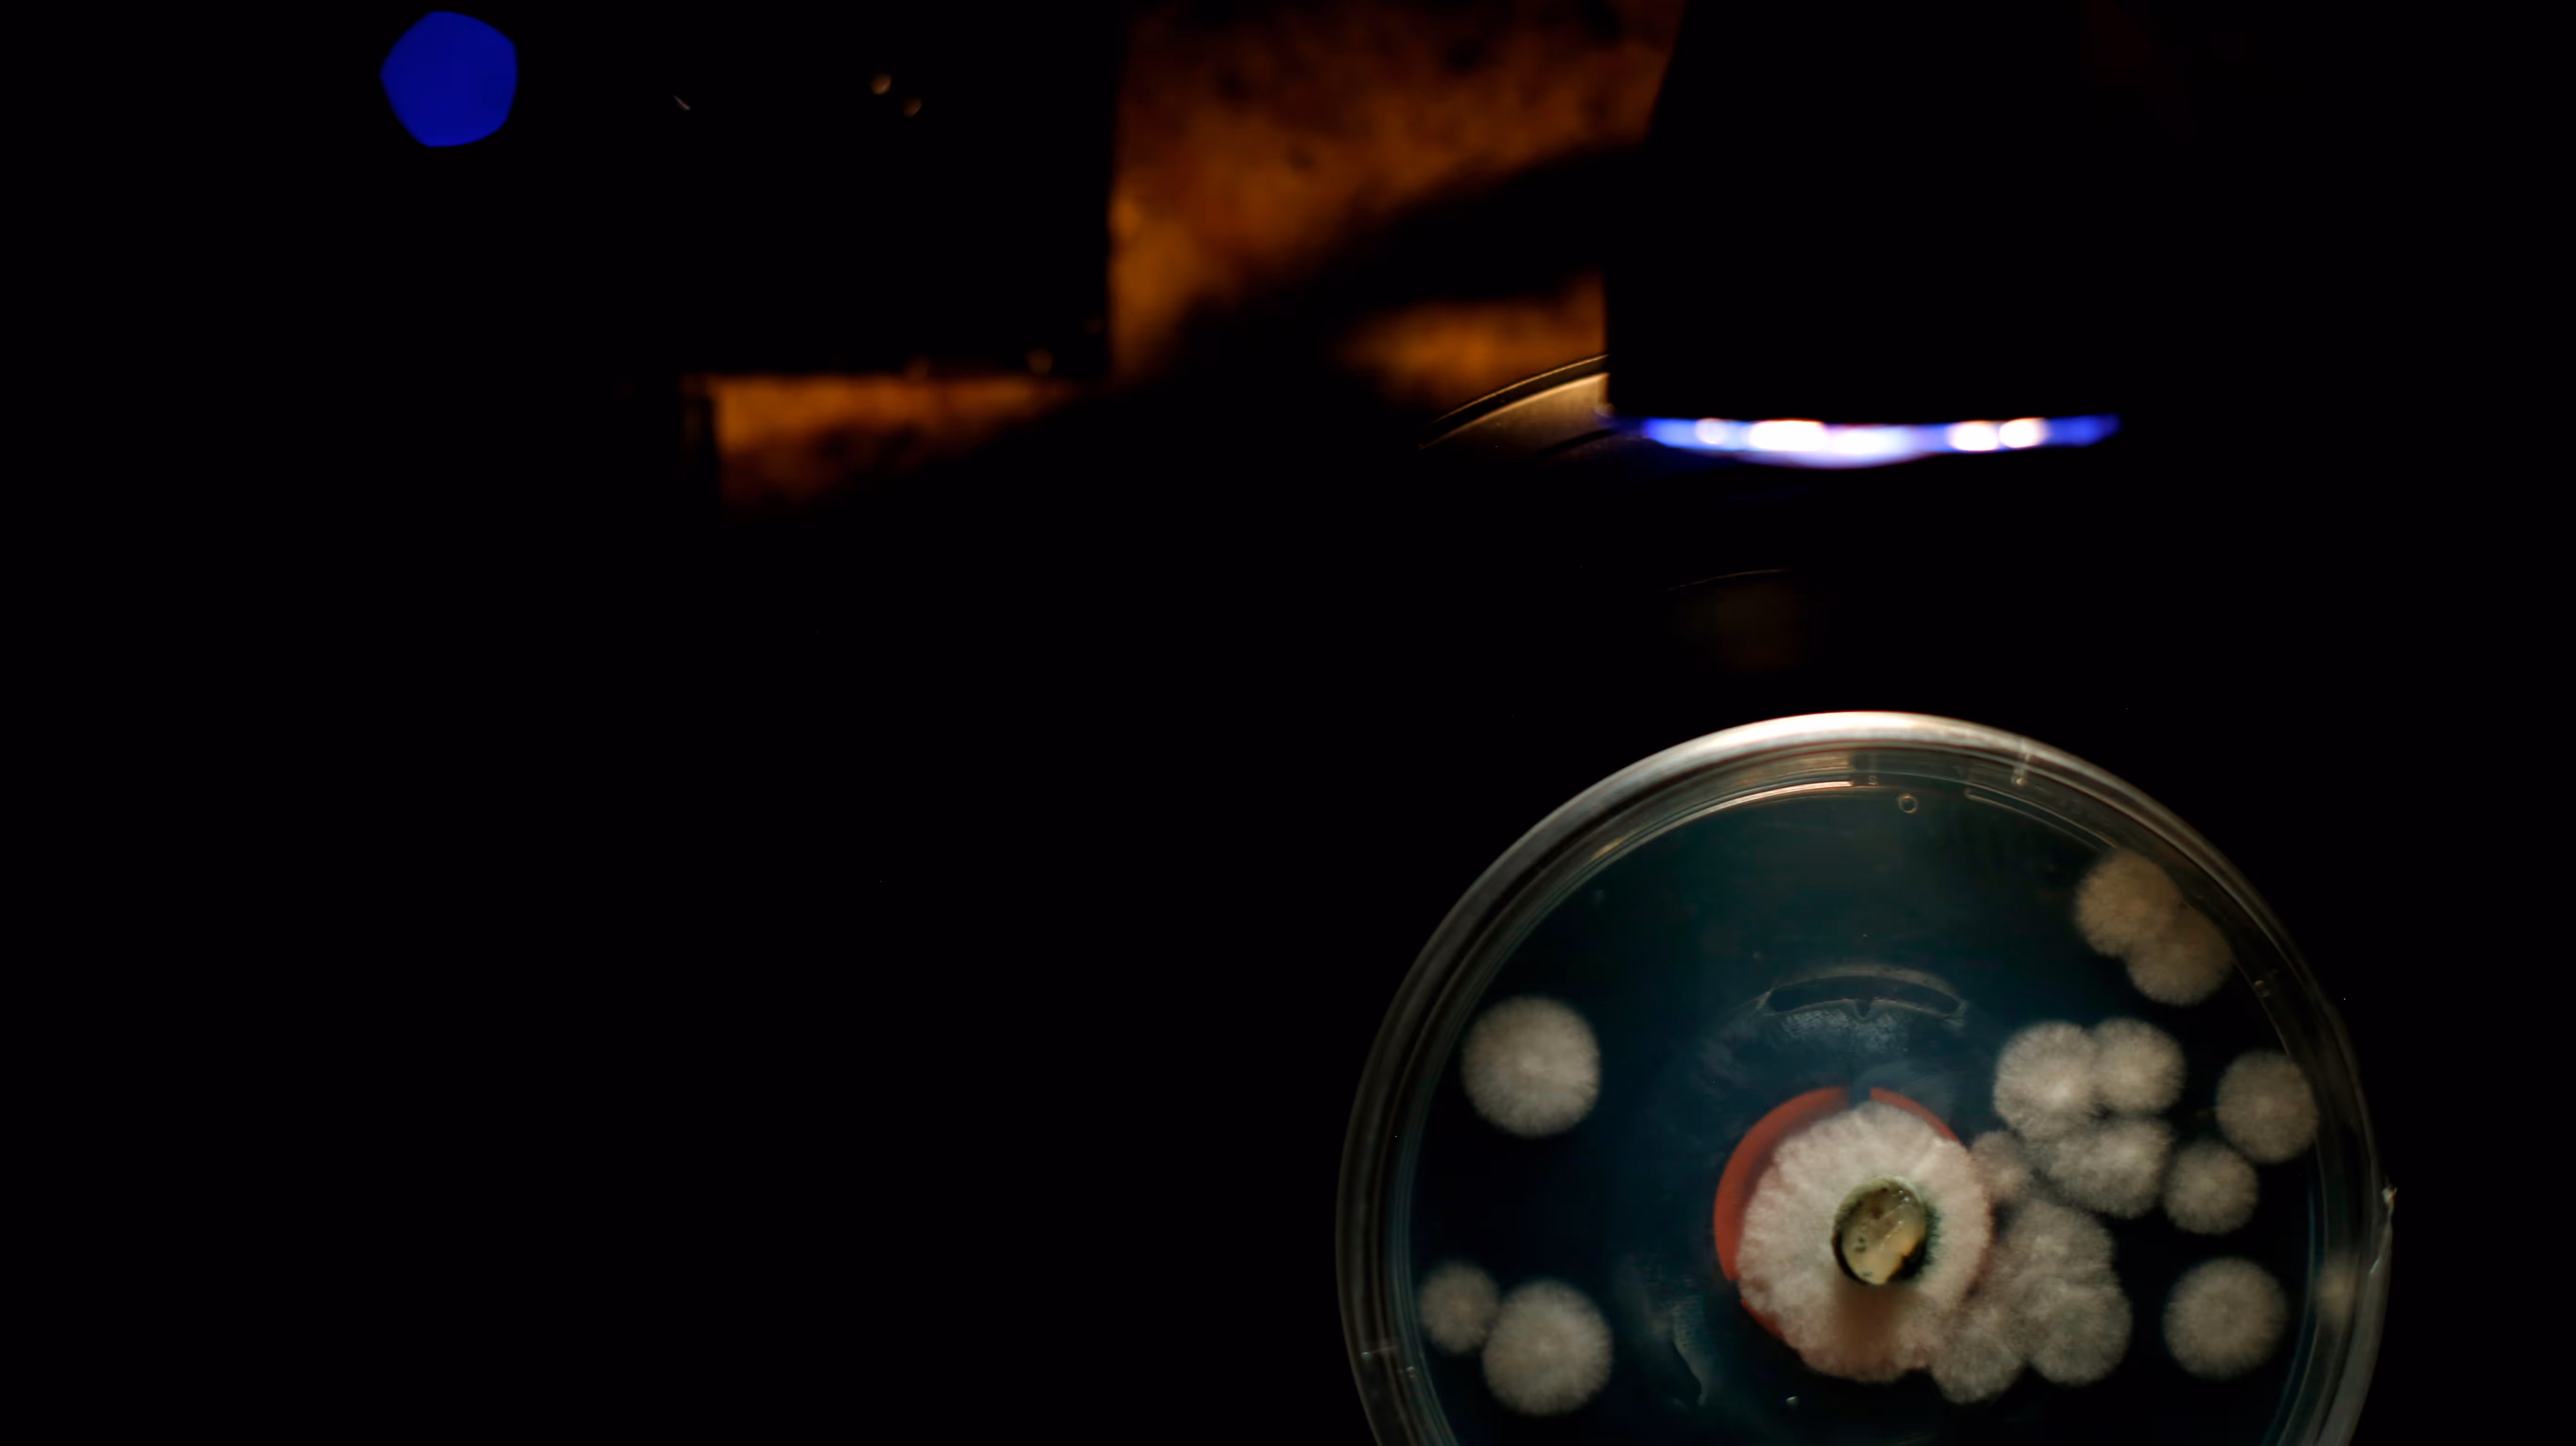

Symbiophone
Jéssica


Refractions
Cells
Drawing inspiration from Walter Benjamin’s ideas on mechanical reproduction and perception, this work investigates how digital apparatuses can expand our sensory
capabilities. The camera, or other technological devices, become an extension of vision, unveiling layers of reality beyond what the naked eye perceives. Just as microscopy revealed hidden worlds, digital tools allow us to see alternative structures in the everyday, emphasizing the interplay between the organic and the artificial. This project explores how ordinary objects, when seen from new perspectives, can resemble microscopic organisms, revealing reality as an interconnected pattern. The images challenge our perception of the mundane by transforming the familiar into something that can resemble a living cell in a process of division.
The distorted images evoke cell structures, bacteria, or even embryonic forms, questioning the boundaries between the micro and macro, natural and artificial. The contrast between organic-looking shapes and technological intervention invites viewers to reconsider how we define life, perception, and materiality. By manipulating perspective, light, and movement through usage of digital tools, Cells encourages a deeper reflection on how the mechanisms of perception shape our understanding of the world. The project seeks to bridge scientific observation with artistic experimentation, revealing a hidden continuity between the visible and the imperceptible.

%2520se%2520elas%2520houverem%252C%2520a%2520gente%2520vai%2520tira%25CC%2581-las%25E2%2580%259D_001.avif)





























